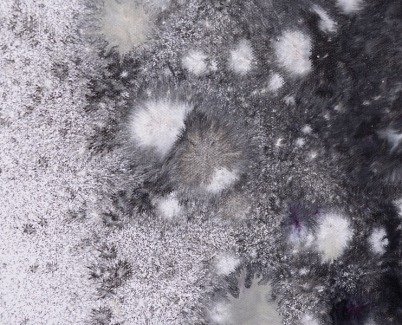
close-up of Resurrection art

A moody, black and white painting inspired by the works of HR Giger
Resurrection is a dark and brooding original artwork that takes some of its inspiration from the artist who created the aliens for the Aliens film franchise.
Firstly let me say that this all-new piece of modern art is not necessarily as dark and twisted as you might think; instead I think it’s more of an expression of what I can do with just black, white and a hint of purple (and an adoration of the drawings of HR Giger – from whom this painting is inspired).
He’s probably most famous for his work on the Aliens film franchise and it’s fair to say that’s where I know his work from. However, the shapes and forms shouldn’t really suggest aliens like the ones in the films; I prefer to think of the darkness as an embryonic development of life – in whatever form that suggests to you.
Some of the detailing is fantastic and I have worked very hard on this to avoid a black sludgy mess at all costs. It’s extraordinarily beautiful as you move closer in to it.
If you aren’t a fan of light and dark, and the paradigms it manifests, then at least appreciate the technique in achieving effects like fur, teeth and bones – things people have told me they see in it. On a positive note I like to believe that Resurrection is a painting full of hope; a notion that all life can be re-created in a constant cycle of regeneration.
I used six new techniques on this one; having gone through a number of experimental stages before committing to a finished piece I considered good enough to make public. I practice very hard to make the difficult things look easy. Try covering 23sqft with a 3ml syringe…